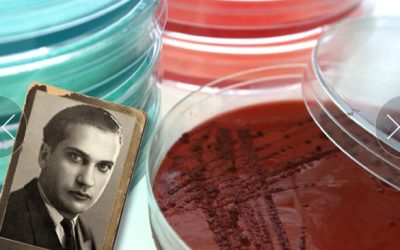

Prensa
-
2025: Un año de consolidación hacia el futuro
En la Fundación Jacinto Convit (FJC) nos complace culminar un año de consolidación e impulso al d...
-
2024: Un año de impulso al desarrollo social
En la Fundación Jacinto Convit (FJC) nos complace finalizar un año de impulso al desarrollo socia...
-
2023: Un año de trascendencia
En la Fundación Jacinto Convit (FJC) nos complace finalizar un año de trascendencia, celebrando i...
-
2022: Una década de esfuerzo y perseverancia
En la Fundación Jacinto Convit (FJC) nos complace finalizar el año celebrando una primera década ...
-
Resumen de ConvitVax
El cáncer es la segunda causa de muerte en la población a nivel mundial; específicamente, el cánc...
-
La FJC amplía su impacto social
Tras nueve años de historia al servicio de la población más vulnerable del país, la Fundación Jac...
-
Celebración del 9°. Aniversario FJC
La Fundación Jacinto Convit (FJC) cumple 9 años al servicio de la población más vulnerable del pa...
-
Nueva publicación científica en el desarrollo de ConvitVax
La Fundación Jacinto Convit (FJC) se complace en anunciar la publicación de su último trabajo de ...
-
2021: Un año de crecimiento
Gracias al apoyo de un gran número de empresas, organizaciones, estudiantes, colaboradores y un t...
-
Acto conmemorativo del legado del Dr. Convit
Este acto conmemorativo dio inicio con unas palabras de nuestra Líder en Captación y Relaciones I...
-
2020 Un Año de Perseverancia
Pese a que el año 2020 ha representado un gran reto para la humanidad, la Fundación continúa desa...
-
2019 Un Año de Impacto Social
Estimados amigos, hoy queremos compartir con ustedes un resumen de todos los logros alcanzados en...
-
Nueva Publicación en Cáncer de Mama
Actualmente la combinación de inmunoterapias para el tratamiento del cáncer es una estrategia ter...
-
Gobierno del Japón beneficia a la Fundación Jacinto Convit
El pasado 13 de febrero de 2019 en la Embajada del Japón en Caracas se realizó el acto de firma d...
-
Boletín: 2018 Un Año de Avances
Gracias al apoyo de cientos de aliados y colaboradores, en el transcurso del 2018 logramos import...
-
Reporte sobre el desarrollo de una vacuna personalizada para el tratamiento del cáncer de mama diseñada por el doctor Jacinto Convit
El cáncer es la segunda causa de muerte en la población a nivel mundial; específicamente, el cánc...
-
Celebrando nuestros primeros 6 años de gestión
¡Hoy estamos de aniversario! Cumplimos 6 años desde que constituimos la Fundación Jacinto Convit ...
-
Jacinto Convit: Una vida al servicio de la humanidad
A cuatro años del fallecimiento del insigne Dr. Jacinto Convit, denominado "Héroe de la Salud Púb...
-
Fundación Jacinto Convit publica estudio científico de relevancia internacional en cáncer de mama
El Dr. Jacinto Convit ha dejado un legado de valores y enseñanza de profundo amor al prójimo, sac...
-
¡Feliz Navidad y Próspero 2018!
El Dr. Jacinto Convit ha dejado un legado de valores y enseñanza de profundo amor al prójimo, sac...
-
Boletín: 2017 Promoviendo Valores a Través de la Ciencia
Este año representa un hito para la organización, el impulso de los programas educativos que tien...
-
Continúa el legado humanista del Dr. Jacinto Convit
El Doctor Jacinto Convit fue un hombre de ciencias que siempre tuvo un claro enfoque humanista. S...
-
En video: Nuestros inicios, logros y visión
Presentamos un breve video que resume los inicios de la Fundación Jacinto Convit, sus logros más ...
-
La Fundación Jacinto Convit conmemora sus 5 años de trayectoria
La Fundación Jacinto Convit en el marco de la conmemoración de sus 5 años de constitución, realiz...
-
Boletín: 5 Años Rompiendo Paradigmas
Lo que comenzó en el año 2010 con el deseo del Dr. Jacinto Convit de constituir un Centro de Inmu...
-
Boletín: 2016 Un Año de Logros
Este año representa un hito para la organización al inaugurar su sede que es hoy día, el primer c...
-
El Dr. Jacinto Convit es un Icono y Leyenda Latinoamericano
El Dr. Jacinto Convit, ha sido reconocido como uno de los Iconos y Leyendas Latinoamericanos, en ...
-
Inauguración y bendición de nuestra sede
El viernes 9 de septiembre, en el marco del Aniversario 103 del natalicio del Dr. Convit, inaugur...
-
Boletín: Continúa la Obra del Dr. Jacinto Convit
La FJC, fundada en Junio de 2012 e inspirada en la visión de servicio social a través de la cienc...
-
La Fundación Jacinto Convit presenta su video institucional
La Fundación Jacinto Convit presenta su video institucional realizado con el apoyo de estudiantes...
-
Dr. Jacinto Convit: uno de los médicos más influyentes de la historia
Ségún una publicación realizada por el portal Medscape, el médico venezolano Jacinto Convit, se e...
-
Conmemoración del 102 aniversario del natalicio del Dr. Jacinto Convit
Hoy desde la FJC, institución creada para continuar sus investigaciones y proyectos, presentamos ...
-
Avances científicos
En el marco del actual enfoque mundial en el tratamiento del cáncer, conocido como inmunoterapia ...
-
En memoria del Doctor Jacinto Convit
El Doctor Jacinto Convit era un hombre de ciencias que siempre tuvo claro su enfoque humanista de...
-
El comunicado de la Fundación Jacinto Convit ante la muerte del maestro
La Fundación Jacinto Convit, constituida por un equipo multidisciplinario de profesionales de la ...
-
Jacinto Convit, «Héroe de la Salud Pública»
El Dr. Convit, a quien la Organización Panamericana de la Salud con sede en Washington DC designó...
-
Jacinto Convit persigue el sueño de encontrar la cura contra el cáncer
Este ilustre personaje es sinónimo de dedicación y entrega en su labor de investigación sobre div...
-
La FJC amplía su impacto social
En el marco de su noveno aniversario, y como parte de sus esfuerzos por ampliar y fortalecer su i...
2025: Un año de consolidación hacia el futuro
En la Fundación Jacinto Convit (FJC) nos complace culminar un año de consolidación e impulso al desarrollo social, celebrando importantes logros a nivel científico, asistencial, formativo y social, gracias a los esfuerzos y la perseverancia que ha mantenido la institución desde sus inicios y que nos lleva a seguir rompiendo paradigmas.
2024: Un año de impulso al desarrollo social
En la Fundación Jacinto Convit (FJC) nos complace finalizar un año de impulso al desarrollo social del país, celebrando importantes logros a nivel científico, asistencial, formativo y social, gracias a los grandes esfuerzos y la perseverancia que ha mantenido la institución desde sus inicios y que nos lleva a seguir rompiendo paradigmas.
2023: Un año de trascendencia
En la Fundación Jacinto Convit (FJC) nos complace finalizar un año de trascendencia, celebrando importantes avances a nivel científico, asistencial, formativo y social, gracias a los grandes esfuerzos y la perseverancia que ha mantenido la institución desde sus inicios.
2022: Una década de esfuerzo y perseverancia
En la Fundación Jacinto Convit (FJC) nos complace finalizar el año celebrando una primera década de historia con avances importantes a nivel científico, asistencial, formativo y social, gracias a los grandes esfuerzos y la perseverancia que ha mantenido la institución desde sus inicios.
Resumen de ConvitVax
El cáncer es la segunda causa de muerte en la población a nivel mundial; específicamente, el cáncer de mama es el más diagnosticado y mortal en mujeres. Según la American Cancer Society, la tasa de supervivencia a 5 años en pacientes con cáncer de mama en estadio IV es de 28% aproximadamente.
La FJC amplía su impacto social
Tras nueve años de historia al servicio de la población más vulnerable del país, la Fundación Jacinto Convit (FJC) continúa desarrollando programas de alto impacto a fin de beneficiar a quienes más lo necesitan y contribuir con el progreso de la humanidad.
Celebración del 9°. Aniversario FJC
La Fundación Jacinto Convit (FJC) cumple 9 años al servicio de la población más vulnerable del país. Durante este tiempo, ha alcanzado importantes logros.
Nueva publicación científica en el desarrollo de ConvitVax
La Fundación Jacinto Convit (FJC) se complace en anunciar la publicación de su último trabajo de investigación titulado «Toxicity evaluation of ConvitVax breast cancer immunotherapy» en la revista indexada Scientific Reports.
2021: Un año de crecimiento
Gracias al apoyo de un gran número de empresas, organizaciones, estudiantes, colaboradores y un talento humano sólido, competente y comprometido, hemos logrado importantes avances en todas las áreas de acción de la Fundación, como lo son investigación científica, asistencia en salud, formación de profesionales, promoción de valores, proyectos comunitarios, entre otras, lo que ha permitido contribuir con el desarrollo del país.
Acto conmemorativo del legado del Dr. Convit
Este acto conmemorativo dio inicio con unas palabras de nuestra Líder en Captación y Relaciones Institucionales, Mariely Contreras, quien recalcó la importante trayectoria del Dr. Convit en distintos ámbitos que hoy día continúan teniendo un alto impacto en la humanidad.
2020 Un Año de Perseverancia
Pese a que el año 2020 ha representado un gran reto para la humanidad, la Fundación continúa desarrollando arduamente su labor científica, social y educativa, a favor de la población más vulnerable y el desarrollo social del país. Esto es posible gracias al apoyo de todos nuestros aliados, donantes, colaboradores, asesores, estudiantes y un talento humano sólido y comprometido con este esfuerzo.
2019 Un Año de Impacto Social
Estimados amigos, hoy queremos compartir con ustedes un resumen de todos los logros alcanzados en la Fundación Jacinto Convit durante el 2019.
Nueva Publicación en Cáncer de Mama
Actualmente la combinación de inmunoterapias para el tratamiento del cáncer es una estrategia terapéutica poderosa y prometedora que puede conducir a tratamientos más efectivos y eficientes.
Gobierno del Japón beneficia a la Fundación Jacinto Convit
El pasado 13 de febrero de 2019 en la Embajada del Japón en Caracas se realizó el acto de firma de un contrato de donación entre el Gobierno del Japón, representado por su Excelentísimo Embajador Kenji Okada, y la Fundación Jacinto Convit, representada por su Secretaria General Ana Federica Convit.
Boletín: 2018 Un Año de Avances
Gracias al apoyo de cientos de aliados y colaboradores, en el transcurso del 2018 logramos importantes avances en todos los programas y objetivos de la organización; tales como la expansión del servicio de la Unidad de Diagnóstico Molecular, nuevas validaciones en el desarrollo de una terapia personalizada en la Unidad Experimental de Inmunoterapia, la digitalización y restauración de cientos de archivos inéditos para la Biblioteca Digital Jacinto Convit, la promoción de principios bajo el programa educativo Valores a través de la Ciencia, el entrenamiento de un gran número de estudiantes provenientes de todo el territorio nacional, y la capacitación de un equipo humano de excelencia, sólido y comprometido con la misión de la organización.
Reporte sobre el desarrollo de una vacuna personalizada para el tratamiento del cáncer de mama diseñada por el doctor Jacinto Convit
El cáncer es la segunda causa de muerte en la población a nivel mundial; específicamente, el cáncer de mama es el segundo más común. Según la American Cancer Society, la tasa de supervivencia a 5 años en pacientes con cáncer de mama en estadio IV es de 22%, aproximadamente.
Celebrando nuestros primeros 6 años de gestión
¡Hoy estamos de aniversario! Cumplimos 6 años desde que constituimos la Fundación Jacinto Convit (FJC) para preservar, proteger y continuar la obra, proyectos, valores y filosofía del médico, científico y humanista Dr. Jacinto Convit.
Jacinto Convit: Una vida al servicio de la humanidad
A cuatro años del fallecimiento del insigne Dr. Jacinto Convit, denominado «Héroe de la Salud Pública» por la Organización Panamericana de la Salud (OMS), la Fundación Jacinto Convit celebra su vida y legado a través de proyectos científicos, educativos, sociales y comunitarios.
Fundación Jacinto Convit publica estudio científico de relevancia internacional en cáncer de mama
El Dr. Jacinto Convit ha dejado un legado de valores y enseñanza de profundo amor al prójimo, sacrificio, valentía, dedicación, constancia, humildad y sensibilidad, que la Fundación Jacinto Convit promueve para lograr el éxito y desarrollo como sociedad.
¡Feliz Navidad y Próspero 2018!
El Dr. Jacinto Convit ha dejado un legado de valores y enseñanza de profundo amor al prójimo, sacrificio, valentía, dedicación, constancia, humildad y sensibilidad, que la Fundación Jacinto Convit promueve para lograr el éxito y desarrollo como sociedad.
Boletín: 2017 Promoviendo Valores a Través de la Ciencia
Este año representa un hito para la organización, el impulso de los programas educativos que tienen como objetivo infundir los valores y filosofía de vida del Dr. Jacinto Convit, para despertar un espíritu curioso y crítico que motive a consolidar grandes sueños y proyectos en Venezuela.
Continúa el legado humanista del Dr. Jacinto Convit
El Doctor Jacinto Convit fue un hombre de ciencias que siempre tuvo un claro enfoque humanista. Se dedicó a curar las enfermedades más temibles y olvidadas de los pueblos como lepra, leishmaniasis y cáncer, así como a la atención integral del paciente. Se avocó a educar y trabajar en equipo, siendo un ferviente creyente de la importancia de capacitar a nuevas generaciones.
En video: Nuestros inicios, logros y visión
Presentamos un breve video que resume los inicios de la Fundación Jacinto Convit, sus logros más relevantes y la visión de su equipo de trabajo, como homenaje a sus 5 años de creación.
La Fundación Jacinto Convit conmemora sus 5 años de trayectoria
La Fundación Jacinto Convit en el marco de la conmemoración de sus 5 años de constitución, realizó el viernes 14 de julio un Acto de Rendición de Cuentas y Reconocimientos.
Boletín: 5 Años Rompiendo Paradigmas
Lo que comenzó en el año 2010 con el deseo del Dr. Jacinto Convit de constituir un Centro de Inmunoterapia de Cáncer en el país para disminuir los índices de mortalidad de está enfermedad, se ha materializado en la Fundación Jacinto Convit que desde su constitución en junio del año 2012, continúa su obra y proyectos.
Boletín: 2016 Un Año de Logros
Este año representa un hito para la organización al inaugurar su sede que es hoy día, el primer centro de investigación científica independiente, sin fines de lucro, al servicio de la salud pública en Venezuela. La FJC se creó para preservar, proteger y continuar la obra, proyectos, valores y filosofía del médico, científico y humanista Dr. Jacinto Convit.
El Dr. Jacinto Convit es un Icono y Leyenda Latinoamericano
El Dr. Jacinto Convit, ha sido reconocido como uno de los Iconos y Leyendas Latinoamericanos, en la tercera edición del Premio Regional Innovadores de América 2016.
Inauguración y bendición de nuestra sede
El viernes 9 de septiembre, en el marco del Aniversario 103 del natalicio del Dr. Convit, inauguramos y bendecimos la nueva sede de nuestra Fundación para continuar con el legado del reconocido científico humanista.
Boletín: Continúa la Obra del Dr. Jacinto Convit
La FJC, fundada en Junio de 2012 e inspirada en la visión de servicio social a través de la ciencia, continúa abocada al desarrollo de una inmunoterapia (autovacuna) para el tratamiento de cáncer de mama, y otros tipos de cáncer, diseñada por el Dr. Convit durante sus últimos años de vida.
La Fundación Jacinto Convit presenta su video institucional
La Fundación Jacinto Convit presenta su video institucional realizado con el apoyo de estudiantes de Comunicación Social de la Universidad Católica Andrés Bello, en el cual se muestran las instalaciones y el trabajo científico- social que se lleva a cabo en la organización.
Dr. Jacinto Convit: uno de los médicos más influyentes de la historia
Ségún una publicación realizada por el portal Medscape, el médico venezolano Jacinto Convit, se encuentra entre los médicos más influyentes de la historia de la humanidad junto al español Ramón y Cajal y otros destacados médicos ganadores del Nobel como Severo Ochoa de Albornoz, Albert Schweitzer, entre otros.
Conmemoración del 102 aniversario del natalicio del Dr. Jacinto Convit
Hoy desde la FJC, institución creada para continuar sus investigaciones y proyectos, presentamos una ilustración de su larga y ejemplar vida que durante un siglo estuvo llena de eventos importantes que lo llevaron a convertirse en uno de los venezolanos más insignes y queridos de nuestra historia.
Avances científicos
En el marco del actual enfoque mundial en el tratamiento del cáncer, conocido como inmunoterapia del cáncer, es para nosotros un placer compartir un importante logro con ustedes, basado en un inmenso esfuerzo que realiza la Fundación Jacinto Convit para dar continuidad y preservar los importantes trabajos que hiciera en vida el científico humanista, Dr. Jacinto Convit.
En memoria del Doctor Jacinto Convit
El Doctor Jacinto Convit era un hombre de ciencias que siempre tuvo claro su enfoque humanista de la medicina. Se dedicó a curar las enfermedades más temibles y olvidadas de los pueblos, y a la atención integral del paciente.
El comunicado de la Fundación Jacinto Convit ante la muerte del maestro
La Fundación Jacinto Convit, constituida por un equipo multidisciplinario de profesionales de la Salud y las Ciencias Sociales cuyo objetivo es darle continuidad a su legado, emitió un comunicado donde resalta la vida y obra del maestro fallecido este lunes.
Jacinto Convit, «Héroe de la Salud Pública»
El Dr. Convit, a quien la Organización Panamericana de la Salud con sede en Washington DC designó «Héroe de la Salud Pública» en 2002, fue un especialista de renombre mundial en la lepra (enfermedad de Hansen) y enfermedades tropicales.
Jacinto Convit persigue el sueño de encontrar la cura contra el cáncer
Este ilustre personaje es sinónimo de dedicación y entrega en su labor de investigación sobre diversas enfermedades endémicas
La FJC amplía su impacto social
En el marco de su noveno aniversario, y como parte de sus esfuerzos por ampliar y fortalecer su impacto social, la FJC llevó a cabo su primer proyecto social en beneficio de niños, jóvenes y adultos de la comunidad rural de Palmichal, Edo. Carabobo, con el objetivo de promover una mejor calidad de vida desde el ámbito educativo, ambiental y social, entre los miembros de dicha localidad.